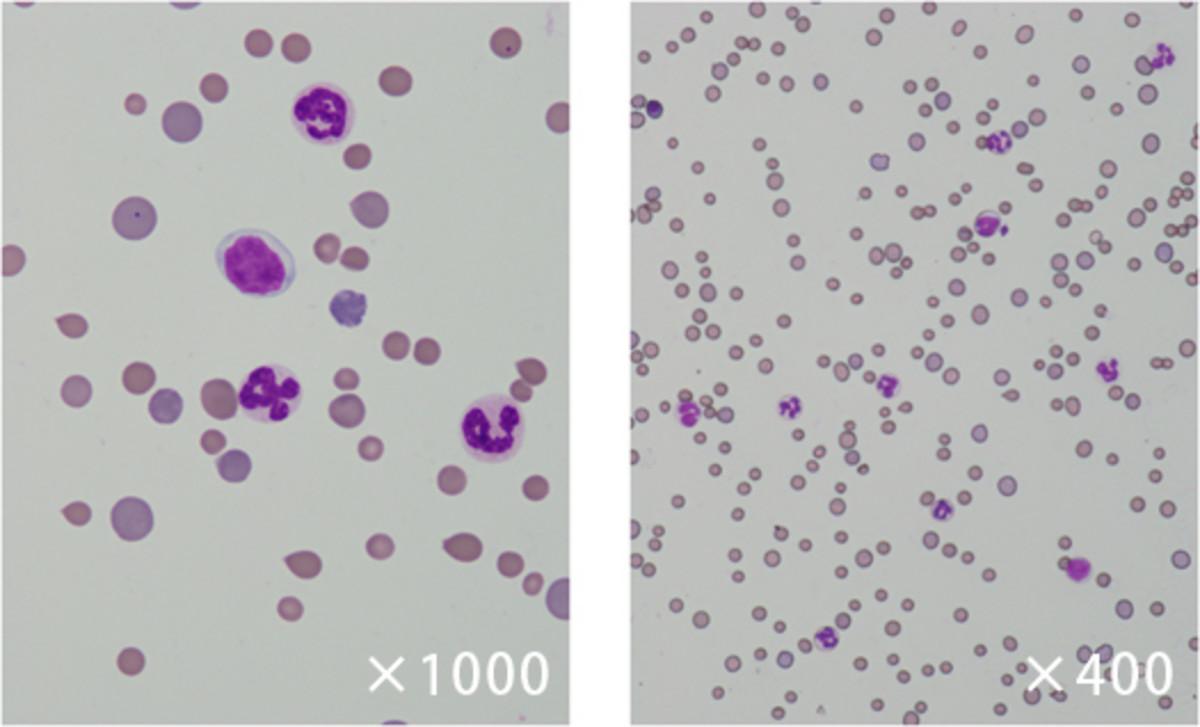

無巨核球性血小板減少症(AMT)は、骨髄における巨核球の無形成または重度低形成を伴う末梢血での血小板減少により特徴づけられる疾患です。本疾患は医学領域でも稀で、獣医領域では極めて少なく、猫での発生率は不明です。猫白血病ウイルス(FeLV)感染に続発性のAMTの猫が当院へ紹介来院したので、その診断と治療の概要を報告します。
雑種猫
未去勢雄、8ヶ月齢、体重2.8kg 室内外飼育
3種混合ワクチン接種
既往歴: 特になし
現病歴: 約2ヶ月前(6ヶ月齢時)に乳歯脱換時に過剰な出血を認め、近医にて診察、重度の血小板減少症と中等度の貧血が認められました。その時のウイルス検査ではFeLV抗原陰性、FIV抗体陰性でした。免疫介在性血小板減少症(IMT)を疑いプレドニゾロン(PDN)やアザチオプリンによる免疫抑制療法にて治療しましたが、反応は乏しく徐々に状態が悪化し、当院に紹介来院しました。
初診時一般身体検査所見:体温37.2℃、可視粘膜蒼白、全身体表に出血斑、歯肉出血、黒色便を認めました(図1)。体表リンパ節の腫大は認められませんでした。
初診時血液検査所見:CBCでは左方移動を伴う好中球増加、重度の貧血、重度の血小板減少を認めました(表1)。
図1:体表の出血斑
表1:第1病日CBC所見
* ANC: all nucleated cells.総有核細胞数(NRBCを含む)。
血液化学検査ではGlu、LDH、BUN、Pの上昇を認めました(表2)。凝固系検査は異常を認めませんでした(表3)。
表2:第1病日血液化学検査所見
表3:凝固系検査所見
血液塗抹検査所見:血小板は著明に減少しほとんど認められませんでした。赤血球では網赤血球は著しく増加し、有核赤血球も出現していました(図2)。
図2:血液塗抹
尿検査: 比重1.040、pH6.5、蛋白+、潜血−、沈査なし
画像検査所見:胸部、腹部X線検査と腹部超音波検査では異常を認めませんでした。
骨髄検査所見:骨髄は正形成髄で骨髄球系と赤芽球系は正形成であり、赤芽細胞増加はなく、異形成所見は赤芽球に軽度に認められました。巨核球系はほとんど認められず重度低形成でした(図3、表4)。
図3:骨髄塗抹
表4:骨髄細胞百分比%
骨髄クロット検査:正形成髄であり、赤芽球系と骨髄球系は正形成でした。中等度の線維化が認められました。巨核球系細胞はほとんど観察されませんでした(図4)。
図4:骨髄組織検査
猫ベクター媒介性疾患パネル Anaplasma phagocytophilum, Anaplasma platys, Bartonella spp, Cytauxzoon felis, Ehrlichia canis, Ehrlichia ewingii, Ehrlichia chaffeensis, Mycoplasma haemofelis, Candidatus Mycoplasma haemominutum, Candidatus Mycoplasma turicensis の遺伝子検査はすべて陰性でした。
ウイルス検査:FeLV抗原陽性、FIV抗体陰性
以上の結果よりFeLV感染に続発性の無巨核球性血小板減少症と診断しました。
輸血を行い、PDNとシクロスポリン(CyA)による免疫抑制療法を実施しました。しかし1週間血小板は増加せず、貧血が進行したため再度輸血後ビンクリスチン(VCR)を追加しました。その後血小板は急速に増加し、出血症状も消失、貧血も改善したため第15病日に退院しました。その後は紹介病院にて治療を継続しPDNとCyAを漸減しました(図5)。その後309病日の骨髄再検査では巨核球は十分認められ、異形成所見や腫瘍性に増殖する所見はありませんでした。FeLV抗原は陰性、FIV抗体も陰性でした。
820病日を過ぎましたが、良好に経過しています。
図5:治療と経過
AMTの原因として人で挙げられているものは、内因性幹細胞機能不全、薬物・毒物、感染性因子、免疫介在性メカニズムによる破壊があります。犬では原発性免疫介在性AMTが最も多い原因として報告されています。猫のAMTの複数例報告はなく、その発生率は不明です。猫の血小板減少についての回顧的研究では、原因として原発性免疫介在性は稀であり、感染症と腫瘍性疾患が多く、なかでもFeLV感染が最も多いと報告されています。しかし、その骨髄検査に関する情報は記載されていません。本症例は当院来院時にFeLV感染が確認され、末梢血の血小板減少症と骨髄吸引塗抹および骨髄クロット検査において巨核球系重度低形成で、他の検査所見も含め、FeLV感染に続発性の免疫介在性AMTと診断しました。人の免疫介在性AMTの治療は、グルココルチコイドやアザチオプリン、CyA、人免疫グロブリン(IVIG)、シクロフォスファミド(CPM)、VCR、ダナゾール、抗胸腺グロブリンなどが用いられ、難治例で脾摘や骨髄移植も行われています。Cooperらの犬のAMTとIMTの比較研究では、退院までの死亡率はAMTで86%(6/7)、IMTで15%(5/34)であり、AMTの予後は悪いことが報告されています。猫のAMTの治療報告は僅かであり、人と犬のIMTとAMTを参考に治療を行いました。PDNはIMTの第1選択薬であり、本症例においても紹介元の病院ですでに使用されていました。そこでCyAの併用を開始しました。しかし、出血症状・貧血の進行・頻回輸血などから急を要するため、効果発現の速いVCR、IVIG、CPMを検討し、第8病日にVCRを追加したところ、血小板数の著しい増加を認め、寛解が得られました。AMTへのVCRの使用に関して否定的意見もありますが、明確な根拠となる情報はありません。また本症例は今後も注意深い経過観察が必要です。今後同様の症例に関して、さらなる情報の蓄積が望まれます。
2020年6月掲載
※内容は掲載時点の知見であり、最新情報とは異なる場合もございます。
| 病院名 | 諫早ペットクリニック |
|---|---|
| 住所 | 長崎県諫早市泉町23-9 |
| TEL | 0957-27-0808 |
| 診療動物 | 犬・猫 |
| ウェブサイト | https://www.isahaya-petclinic.com/ |
地図